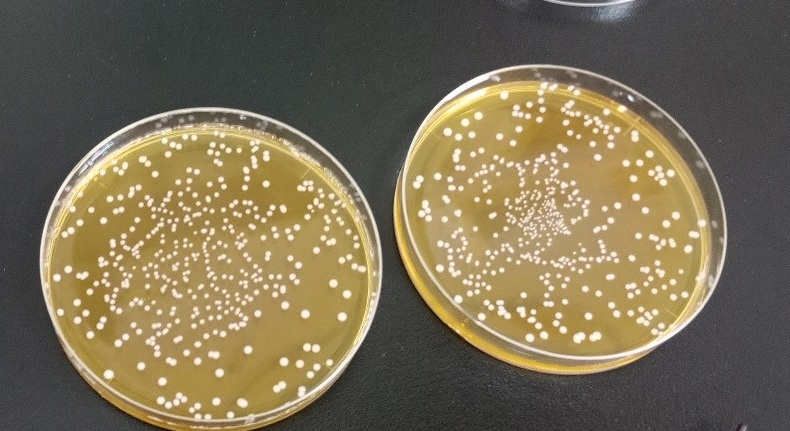

キャベツの芯を発酵させ、粉末にする技術
オンエアレポート
2025.06.19
今回は、こちらに注目します。「キャベツの芯を発酵させ、粉末にする技術」

今回のイノベーターは、群馬県農業技術センター 企画部の江原駿さんです。

「キャベツの芯を発酵させ、粉末にする技術」について、詳しく教えてください。
「通常は廃棄されてしまうキャベツの芯を利用して、東洋大学との共同研究により選ばれた乳酸菌を使って発酵させました。
その後、民間企業との連携を経て、粉末にしたという技術です」
どのような思いがあって、開発したのでしょう?
「捨てられてしまうキャベツの芯を活用したいと考えました」
「これまでに農業技術センターでは、キャベツ酢やザワークラウトというキャベツの発酵食品を開発しており、
嬬恋の農家さんが販売している経緯があります」
「そのことから、キャベツの芯を利用するにあたって、“発酵”をキーワードに進めていたのですが、
芯は香りや繊維などの面から、直接、食品に加工するのは非常に難しかったんです」
「そこで、粉末であれば使いみちが多いのではないかと考え、粉末化を行いました」

発酵させて粉末にすると、どのようなメリットがあるのでしょうか?
「発酵させることによって、機能性成分であるGABAが増加します。
また、乳酸菌入りなので、健康に良い効果が期待できます」
こちらの技術の開発。苦労したのは、どんなことですか?
「キャベツには、非常に多くの乳酸菌が存在するので候補となる株も多いんです」
「そこから優良な株を採取するため、分析の回数が多く、苦労しました」
乳酸菌
こちらの粉末、味が気になりますが、江原さんによりますと、
「ほんのりキャベツの味がしていて、うま味を感じ、何にでも合いそうな気がします」 ということです。
どのように使うことを想定しているのでしょうか?
「風味付けにもなるので、料理の隠し味やキャベツの代わりに使うことを想定しています」
「コンソメスープに入れると、多少の酸味とキャベツの風味を感じることができました」
商品化は、いつごろになりそうですか?
「商品化は未定です。群馬県をもっと盛り上げていきたいので、県内の企業との連携を考えています」

江原さんのお話を伺って、スープに隠し味として使ってみたいと思うと同時に、
もっと使い方を知りたいと思いました。
使い方のバリエーションを増やすこと、そして、その先にある商品化、楽しみに待っています。